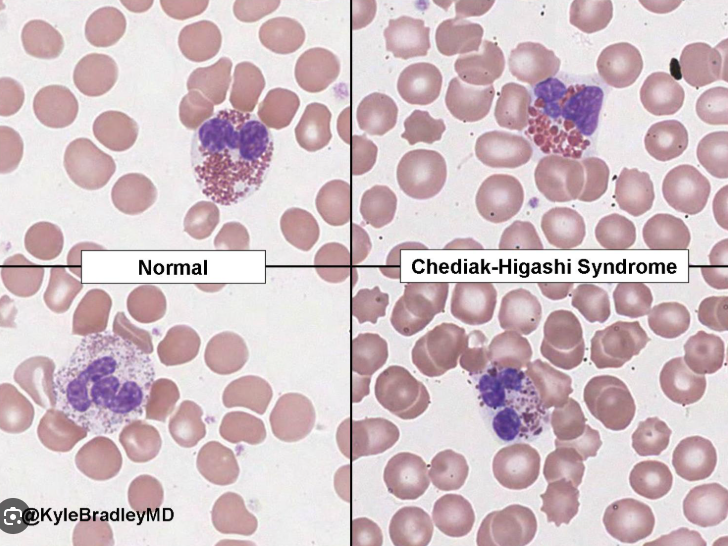

식세포란, 이물질, 체내에 침투한 세균, 죽었거나, 죽어가는 세포등을 섭취하는 세포로,
인체에는 호중구(neutrophile), 단핵구(monocyte), 대식세포(macrophage), 비만세포, 수지상세포와 같은
많은 종류의 백혈구를 포함합니다.
식세포 이상증(Phagocytic dysfunction)은
식세포의 기능이상, 수치이상 등 식세포 기능 자체에 장애가 생기는것으로,
세균을 탐식하거나 살해하는 기능에 이상이 생겨 감염에 취약해지는 선천성 면역결핍 질환을 의미합니다.
이때는 주로 인체의 정상 피부에 존재하는, Staphylococcus aureus 같은 세균 감염이 반복되며,
치료되지 않을 경우 만성 염증, 궤양, 기관 폐쇄 등 심각한 합병증을 유발할 수 있습니다.
이번에는 그중 Chediak-Higashi 증후군 (체디악 히가시),
체디아크 스타인브링크 히가시, 체디아크 히가시 증후군 등으로 불리는
이 질환에 대한 내용입니다.

체디악 히가시 (chediak higashi)증후군은
상염색체 열성(AR)으로 유전되는 질환으로,
호중구에는 아주르친화성 과립이 정상적으로 존재합니다.
이는 다양한 항미생물 방어 물질이 있는 아주르필(azurophil)을 함유하고 있는데,
식작용을 위한 공포와 융합하여, 세균에 대한 방어 작용을 하게됩니다.

이때, 과립 융합 이상 및 탈과립의 장애로 인해 과립이 세포 내 축적되면서,
호중구의 세균에 대한 방어작용이 떨어지게되고, 호중구가 세균이있는 쪽으로 이동하는 능력도 떨어지게됩니다.
lysosomal trafficking regulator (LYST) gene, 즉, 리소좀이라는 세포내 소화기관의 기능을 조절하는 유전자의 장애가 원인입니다.
이로인해 빈번하게 Staphylococcus aureus에 의한 감염이 주로 발생하게됩니다.

그외 호중구의 기능이상뿐아니라, 혈소판에도 이상이발생하게되는데,
혈소판에서도 과립의 기능에 이상이 생기면서 혈소판의 응집이 되지 못하빈다.
이러한 비정상적인 혈소판의 기능으로인해, 잦은 출혈성 경향, 지혈이 잘되지 않는 증상을 보입니다.
그외, 백색증, 운동 실조, 말초 신경병증 등이 동반됩니다.
눈과 피부에 부분적인 백색증이 나타나며,

진행성 말초 신경병증이 동반되어, 지각신경이나 운동신경의 이상, 운동 실조가 발생합니다.
진단 소견은 말초혈액 도말검사에서 peroxidase 양성 거대 과립이 관찰되면, 진단할수 있으며,
이때 과립구에 거대 리소좀이 축적된 소견이 보입니다.

치료는 Ascorbic acid (비타민 C)를 보조적으로 사용하여, 출혈성 경향에 대해서 도움을 주면서
근본적 치료는 골수이식(BMT)입니다.

이상으로 체디악 히가시 증후군에 대한 정리입니다.
'소아 면역학' 카테고리의 다른 글
| 만성 육아종 질환(CGD, Chronic Granulomatous Disease) 및 중성구감소증(neutropenia) – 식세포 이상증 면역저하질환 (0) | 2025.07.19 |
|---|---|
| Wiskott-Aldrich Syndrome 아토피와 출혈이 동반되는 유전성 면역결핍 질환 (0) | 2025.07.18 |
| 중증 복합 면역결핍증(SCID) – 선천성 면역결핍의 가장 심각한 형태 (2) | 2025.07.11 |
| DiGeorge syndrome 디조지증후군 디죠지신드롬 CATCH22 세포성 면역결핍 질환 (0) | 2025.07.10 |
댓글